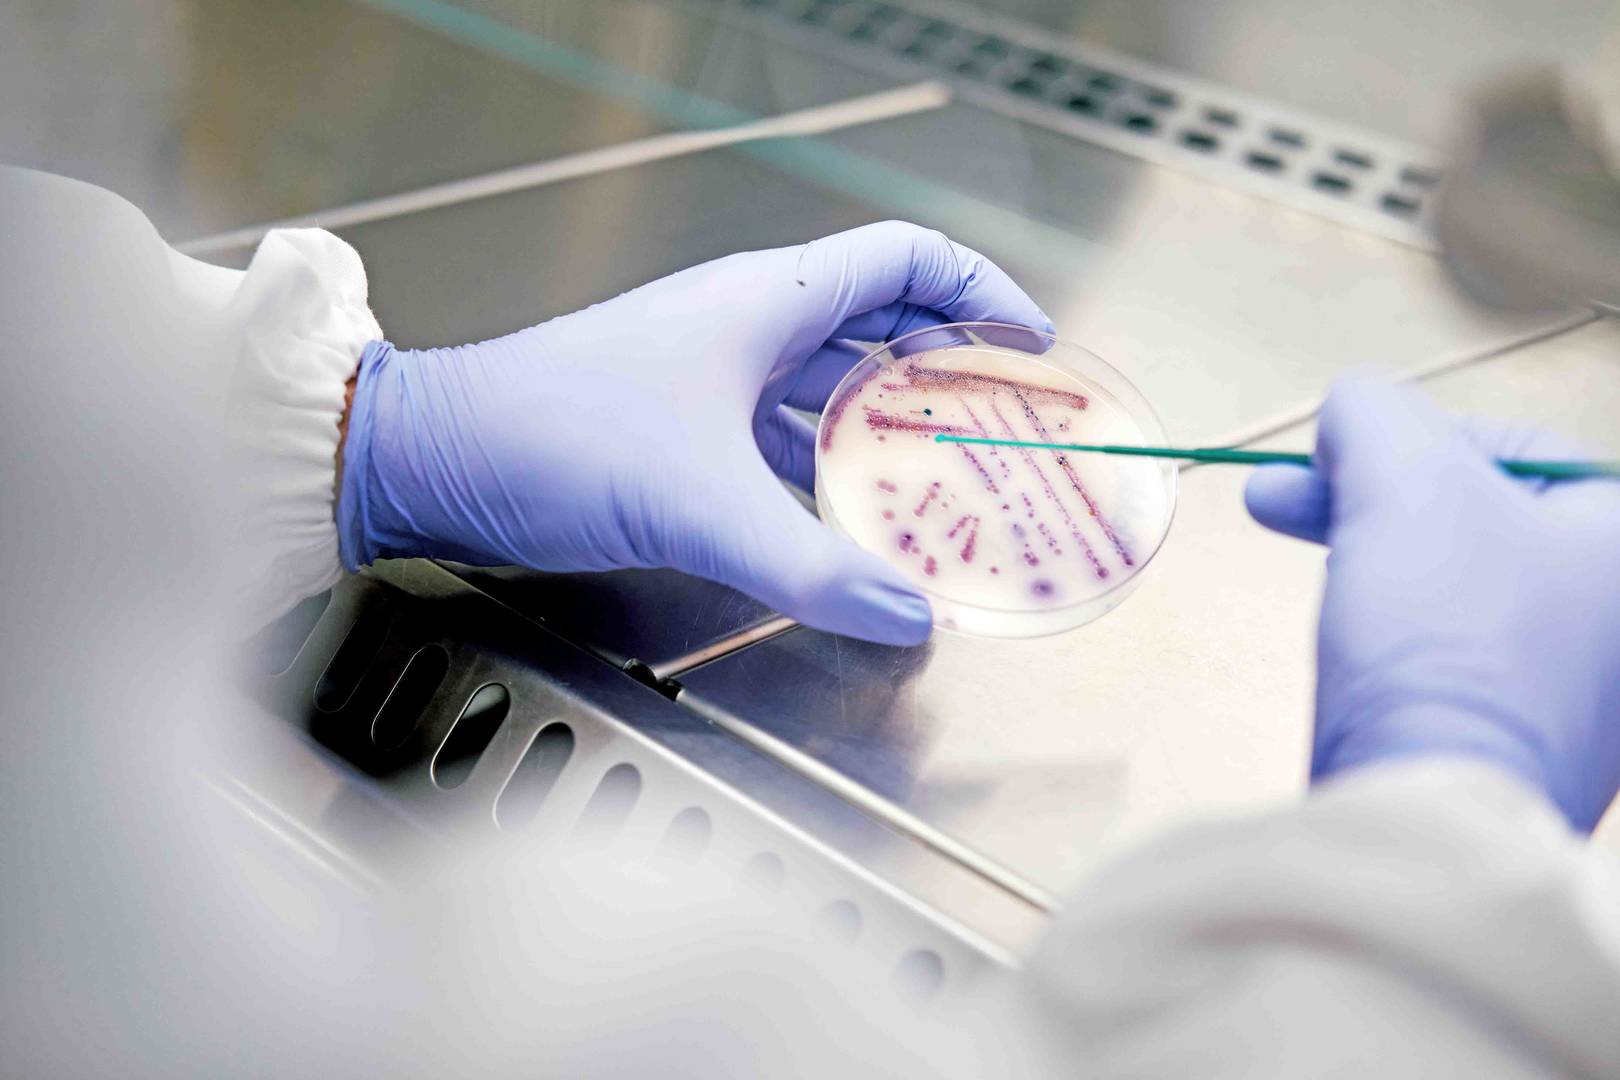
Cientista com luvas e vestuário de proteção a utilizar uma pipeta para analisar culturas bacterianas numa caixa de Petri.

-
 Procurar
Procurar
Search
-
 português
português
-
 Iniciar sessão
Iniciar sessão
ALS Solutions
A ALS Solutions dá-lhe acesso online à sua amostra e informação analítica a partir de qualquer lugar.
Iniciar sessãoGeochemistry WebtrieveTM
Obtenha resultados e acompanhe o progresso das amostras em tempo real com o acesso a produtos digitais em destaque, como o CoreViewer™ e o ALS QCPro™.
Iniciar sessão
Tribology 360
Esta prática aplicação permite aos clientes acompanhar de perto os relatórios de análise de petróleo em curso e em tempo real.
Iniciar sessão